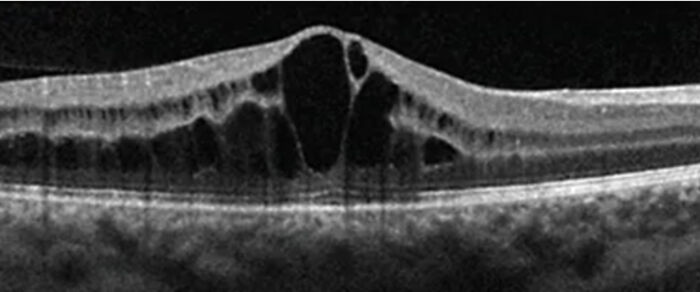

10. tbl. 111. árg. 2025
Umræða og fréttir
Klínísk skoðun og aðferðarfræði. Augnskoðun. Auður Kristín Pétursdóttir og María Soffía Gottfreðsdóttir
Augnskoðun
Hugtakið „augun eru spegill sálarinnar“ á rætur að rekja til fornaldar og hefur sterkar tengingar við gríska heimspeki. Í ritum Platons og Aristótelesar er talað um að sjónin tengist beint sálinni. Litið var á augun sem eins konar glugga eða spegil þar sem hægt væri að skynja hið innra ástand einstaklingsins. Latneska setningin „oculi sunt speculum animae“, eða augun eru spegill sálarinnar, var algeng í rómverskri heimspeki og bókmenntum. Þessi hugsun var því fengin í arf frá Grikkjum eins og margt annað.
Grikkir og Rómverjar voru ekki fjarri sannleikanum. Marga sjúkdóma má sjá í augunum, bæði sjúkdóma sem eiga upptök í augunum sjálfum og sjúkdóma annars staðar í líkamanum. Dæmi um slíka sjúkdóma eru sykursýki, háþrýstingur, skjaldkirtilssjúkdómar, sýkingar og bólgusjúkdómar (til dæmis sárasótt, berklar, HIV, liðagigt, sarklíki). Þá geta ýmsir blóðsjúkdómar, eins og til dæmis hvítblæði, komið fram í augum. Því skiptir sjúkra- og heilsufarssaga miklu máli en góð og nákvæm augnskoðun er lykilatriði í starfi augnlækna og forsenda fyrir réttri greiningu og meðferð.
Algengustu augnsjúkdómar sem augnlæknar fást við eru: gláka, ský á augasteini og augnbotnahrörnun. Á síðustu árum hafa orðið gríðarlegar framfarir í greiningu og meðferð augnsjúkdóma.
Auganu er skipt í þrjú lög. Yst er trefjahjúpur sem samanstendur af hornhimnu og hvítu. Miðlagið er æðahjúpur sem samanstendur af æðu, brárkleggi og lithimnu. Innst er sjónhimnan, stundum kölluð taugalag, en hún samanstendur af taugafrumum og einföldu litþekjulagi.4 Augnskoðun felst í mati á augnumgjörð, augnhreyfingum, sjónskerpu, litarskyni, augnþrýstingi og sjónsviði ásamt smásjárskoðun í raufarlampa (slitlampa), þar sem hægt er að skoða nákvæmlega fremri og aftari hluta augans.1
Mat augnhreyfinga
Augnhreyfingum er stjórnað af sex vöðvum sem ítaugaðir eru af heilataugum III, IV og VI.
Læknir heldur fingri eða penna í um það bil 30 cm fjarlægð og sjúklingur er beðinn um að fylgja fingrinum eftir þegar læknir færir hann upp, niður, til hliðar og á ská í svokallað „H-munstur“.5
Mæling sjónskerpu
Við mælingu á sjónskerpu (visual acuity) er yfirleitt notast við snellen- eða LogMAR-spjöld þar sem sjúklingurinn situr sex metrum frá spjaldinu og heldur fyrir augað sem ekki er verið að mæla. Full sjónskerpa er 1.0. Mikilvægt er að mæla sjónina með gleraugum eða linsum ef sjúklingurinn notar slíkt.
Geti einstaklingur ekki lesið efstu línuna á spjaldinu er framkvæmd fingurtalning í eins metra fjarlægð. Ef það gengur ekki er kannað hvort sjúklingur sjái handahreyfingar og síðast er ljósnæmi athugað.5
Skoðun litarskyns
Litarskyn er hæfileikinn til að greina og aðgreina mismunandi liti eftir bylgjulengd ljóss. Til að athuga litarskyn er algengast að nota Ishihara-spjöld sem greina rauð-græn litblindu.5
Sjónsviðsathugun
Sjónsviðsmæling (visual field assessment/perimetria) er rannsókn sem er notuð til að mæla hvað sjúklingur sér til hliðanna (jaðarsjón) og hvernig sjónin dreifist yfir allt sjónsviðið. Sjónsviðsmæling er sérstaklega mikilvæg til að fylgjast með sjúkdómum sem geta valdið skemmdum á sjóntaug eða sjónbrautum í heila.
Algengast er að nota svokallaða automatiska sjónsviðsmælingu (Humphrey eða Octopus) en einnig er í sumum tilfellum notuð handvirk sjónsviðsmæling, Goldman-sjónsviðsmæling.
Ef ekki eru tiltæk sjónsviðsmælitæki má gera grófa sjón-sviðsskoðun með því sem kallað er andstæð sjónsviðsskoðun (confrontation visual field testing) eða til að meta miðlægt sjónsviðstap má nota svokallað Amsler-próf sem er kort með rúðustrikuðum línum og metur þá sjúklingurinn hvort línurnar eru beinar eða bognar og bjagaðar.3
Mæling augnþrýstings
Augnþrýstingur (intraocular pressure) er sá kraftur sem þarf til að fletja út yfirborð hornhimnunnar. Hann er yfirleitt mældur með þrýstingsmæli (tonometer).
Eðlileg gildi eru um 10-22 mmHg hjá flestum en það er mikilvægt að hafa í huga að þeir sem eru með þunna hornhimnu mælast oft falskt lágir og þeir sem eru með þykka hornhimnu geta mælst falskt háir.
Talsverð dægursveifla er til staðar, sérstaklega hjá glákusjúklingum, en þrýstingurinn er yfirleitt hæstur á morgnana.
Hækkaður þrýstingur er sterkasti áhættuþáttur gláku. Of lágur þrýstingur getur verið merki um gat á auga (perforation).
Mat á sjáöldrum
Sjáaldrið á að vera hringlaga og samhverft. Óeðlileg lögun getur verið meðfædd, vegna sjúkleika (til dæmis vegna samvaxta í tengslum við lithimnubólgu) eða slysa.
Skoðun í raufarlampa
Raufarlampi gerir lækni kleift að skoða augað í þrívídd af mikilli nákvæmni þar sem stækkun er yfirleitt 10x40x. Hægt er að stjórna breidd, hæð og horni ljósgeislans til að skoða mismunandi hluta augans.2
Við skoðun í raufarlampa er hægt að meta fremri hluta augans, svo sem slímhúð, hornhimnu, forhólf, lithimnu og augastein.
Við skoðun á aftari hluta augans eru notaðar sérstakar augnbotnalinsur. Einnig eru oft gefin sjáaldursútvíkkandi lyf til að fá sem nákvæmasta mynd af sjónhimnunni, sjóntauginni, gula blettinum og æðum.3
Í dag er sneiðmyndataka, OCT (Optical Coherence Tomo-graphy), lykilrannsókn í augnbotnaskoðun. OCT er myndgreiningartækni sem notar ljósbylgjur (ekki röntgen eða hljóð) til að búa til mjög nákvæmar sneiðmyndir af auganu, sérstaklega sjónhimnu, sjóntaug og gula blettinum. OCT-tæknin hefur valdið byltingu í greiningu og eftirfylgni margra augnsjúkdóma.
Heimildir
1. Björnsson, ÓM. (2005) Hrörnun í augnbotnum. Læknablaðið. Sótt af https://www.laeknabladid.is/2005/07/nr/2065#Liffaerafraedi
2. EyeWiki. (2025). Slit Lamp Examination. Ophthalmic Photography. https://eyewiki.org/Slit_Lamp_Examination
3. UCSD Medical Education. (n.d.). Eye Examination. https://meded.ucsd.edu/clinicalmed/eyes.html
4. Zhang, X., et al. (2010). Fundus examination. In NCBI Bookshelf. National Center for Biotechnology Information. https://www.ncbi.nlm.nih.gov/books/NBK53329/
5. Root, T. (2009). Ophthalmology. TimRoot.com. https://timroot.com/ophthobook/
6. Retinal Physician. (2017, September). Treatment of uveitic macular edema. https://www.retinalphysician.com/issues/2017/september/treatment-of-uveitic-macular-edema/

Mynd 1. Skoðun í raufarlampa. Sérnámslæknar gáfu leyfi fyrir mynd af sér.

Mynd 2. Heilbrigt auga. Efri: Augnbotnamynd. Neðri: OCT af gula blettinum og sjóntaug.
Mynd 3. OCT sýnir blöðru-sjónudepilsbjúg (cystoid macular edema, CME) sem getur orsakast meðal annars af sykursýki, bólgusjúkdómum í auga, bláæðalokun í sjónhimnu eða eftir augasteinaskipti.6
